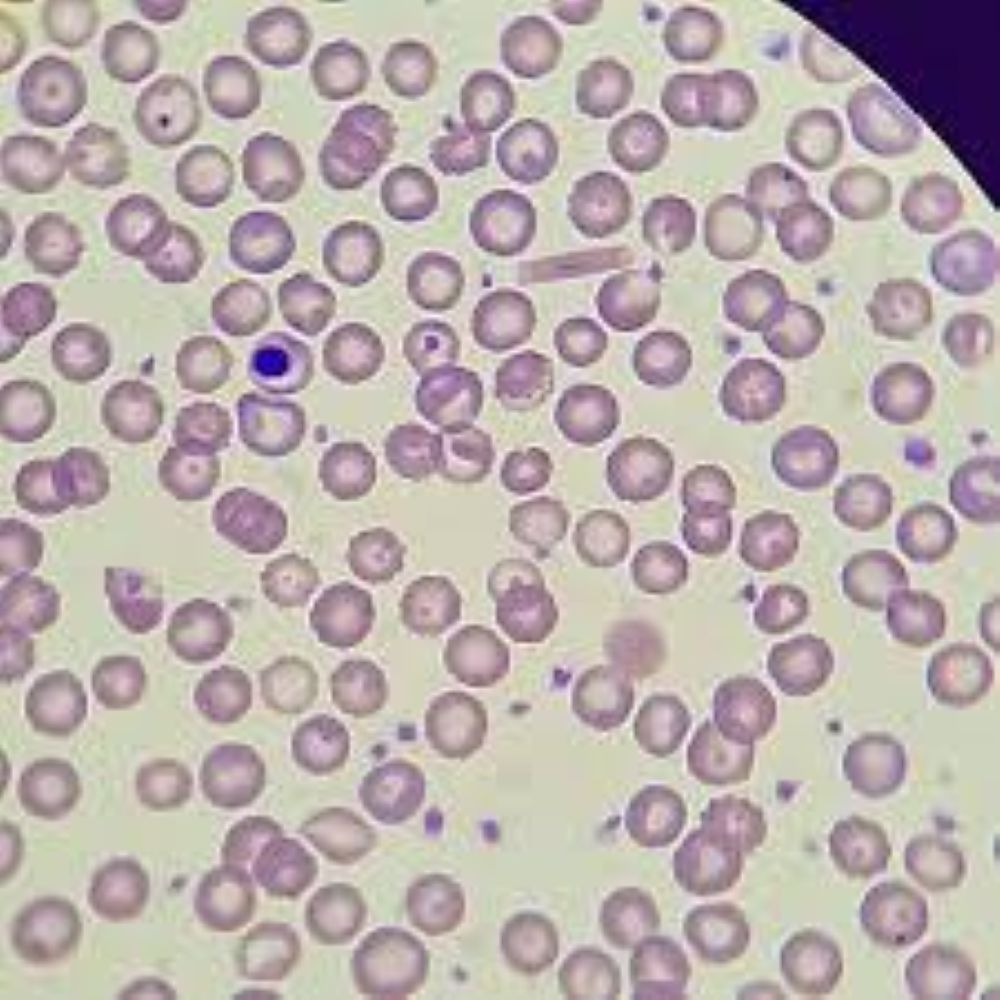
Hemoparasitas

Curso sobre Hemoterapia em Cães e Gatos 🩸
Domine uma das mais valiosas ferramentas terapêuticas em cães e gatos em apenas 50 horas com o Dr. Abílio. 🩸
Aprofunde seus conhecimentos em hemoterapia com o primeiro veterinário em Porto Alegre a trabalhar 24 horas, em finais de semanas e feriados, e isso fez toda a diferença para que ele obtivesse pleno conhecimento em transfusão sanguínea em cães e gatos.
No curso você Médico Veterinário(a) aprenderá em apenas 2 Módulos (50 horas):
– Coleta de sangue de cães e gatos;
– Testes de compatibilidade;
– Diagnóstico e tratamento das anemias;
– Diagnóstico e tratamento das quebras de hemostasia (sangramentos);
Doutor Abílio
Clínica Veterinária 24h
Pioneira no serviço de atendimento 24 horas, a Clínica Veterinária Doutor Abílio é expoente em atendimentos emergenciais de cães e gatos desde 1976.
Doutor Abílio
Clínica Veterinária 24h
Pioneira no serviço de atendimento 24 horas, a Clínica Veterinária Doutor Abílio é expoente em atendimentos emergenciais de cães e gatos desde 1976.
hemoterapia 24h
Prestamos Serviço de Hemoterapia 24h por dia!
Fornecimento de bolsas de sangue
Fornecemos e aceitamos doações de bolsas de sangue para o seu melhor amigo!
Taxi PET
Deixamos seu amigo PET em qualquer lugar para você ter ele sempre por perto!
TRABALHE CONOSCO
Procuramos profissionais da Área Médica Veterinária
Banco de Sangue 24 horas
A Clínica trabalha há mais de trinta anos com o fornecimento de bolsa de sangue.
Um dos nossos diferenciais é que temos disponibilidade total de sangue e hemocomponentes para atender nossos colegas na região de Porto Alegre, metropolitana, serra gaúcha, litoral gaúcho e interior do estado.
Serviços
Especializados
A Clínica Veterinária Doutor Abílio conta com uma extensa lista de serviços especializados em diversas àreas da saúde animal.
A eletroquimioterapia em cães e gatos é a combinação de duas técnicas diferentes: a quimioterapia, utilizada em tratamento de neoplasias e a eletroporação. A combinação das duas técnicas tem como intenção potencializar a ação das drogas quimioterápicas, COM AÇÃO LOCAL .
A ortopedia veterinária é uma especialidade que estuda, diagnostica e trata casos de traumatologias (luxações e fraturas) e patologias relacionadas aos ossos, músculos, articulações e ligamentos dos pets. A ortopedia em pequenos animais cuida da estrutura esquelética dos mesmos. A locomoção faz parte da qualidade de vida dos animais.
A hemoterapia é quando se utiliza o sangue total ou os componentes em separado no tratamento. Existe a possibilidade de existirem reações com a incompatibilidade sanguínea ao utilizar o sangue total nos cães e gatos. Mas tendo o diagnóstico da doença que precisa ser tratada pela hemoterapia veterinária, podem ser diminuídas ou até zeradas as chances de haver alguma reação na transfusão. Os testes de tipagem sanguínea e compatibilidade sanguínea atualmente são fundamentais na medicina transfusional.
A oncologia veterinária é a especialidade que cuida e realiza o tratamento do câncer ou neoplasia maligna nos animais. O câncer é considerado a segunda maior causa de mortes em animais domésticos. A oncologia também trata dos tumores benignos.
Increva-se nos nossos
Cursos
Ministrados pelo próprio Doutor Abílio em sua Clínica, os cursos* promovem um ótimo intercâmbio de experiências e informações entre os participantes.
*Exclusivo para Médicos Veterinários
Aprenda a fazer diagnósticos de doenças que podem ser tratadas com a hemoterapia e como utilizá-la a seu favor! Saiba diferenciar os diversos grupos sanguíneos dos animais de pequeno porte e como coletá-los e armazená-los. Tão importante como fornecer sangue a cães e gatos, é diminuir os efeitos negativos potenciais desse maravilhoso recurso.
O Eletrocardiograma veterinário, também conhecido por ECG, é um exame não invasivo e fundamental para a cardiologia. Aprenda a fazer corretamente o ECG para realizar uma análise profunda das atividades cardíacas dos pequenos animais.
Fale Conosco!
Retornaremos assim que possível!
Confira Nossas Últimas Notícias

4 Curiosidades sobre Transfusão em cães e gatos
Saiba 4 curiosidades importantes sobre a transfusão em pets 1- Sistema de grupos sanguíneos para a transfusão o sistema de grupos sanguíneos são distintos entre
pesquisa de hemoparasitas em cães e gatos
saiba sobre a pesquisa de hemoparasitoses nos animais

Anemia Regenerativa e Arregenerativa?
A anemia regenerativa e arregenerativa são dois fatores diferentes que temos que dominar para podermos saber como tratar nossos animais

10 Doenças Graves Que a Vacinação Pode Evitar em Pets
Você sabe quais doenças a vacinação pode evitar para que você tenha uma vida longa com seu pet?
Categorias de Notícias
Compartilhe Nossas notícias nas suas redes: